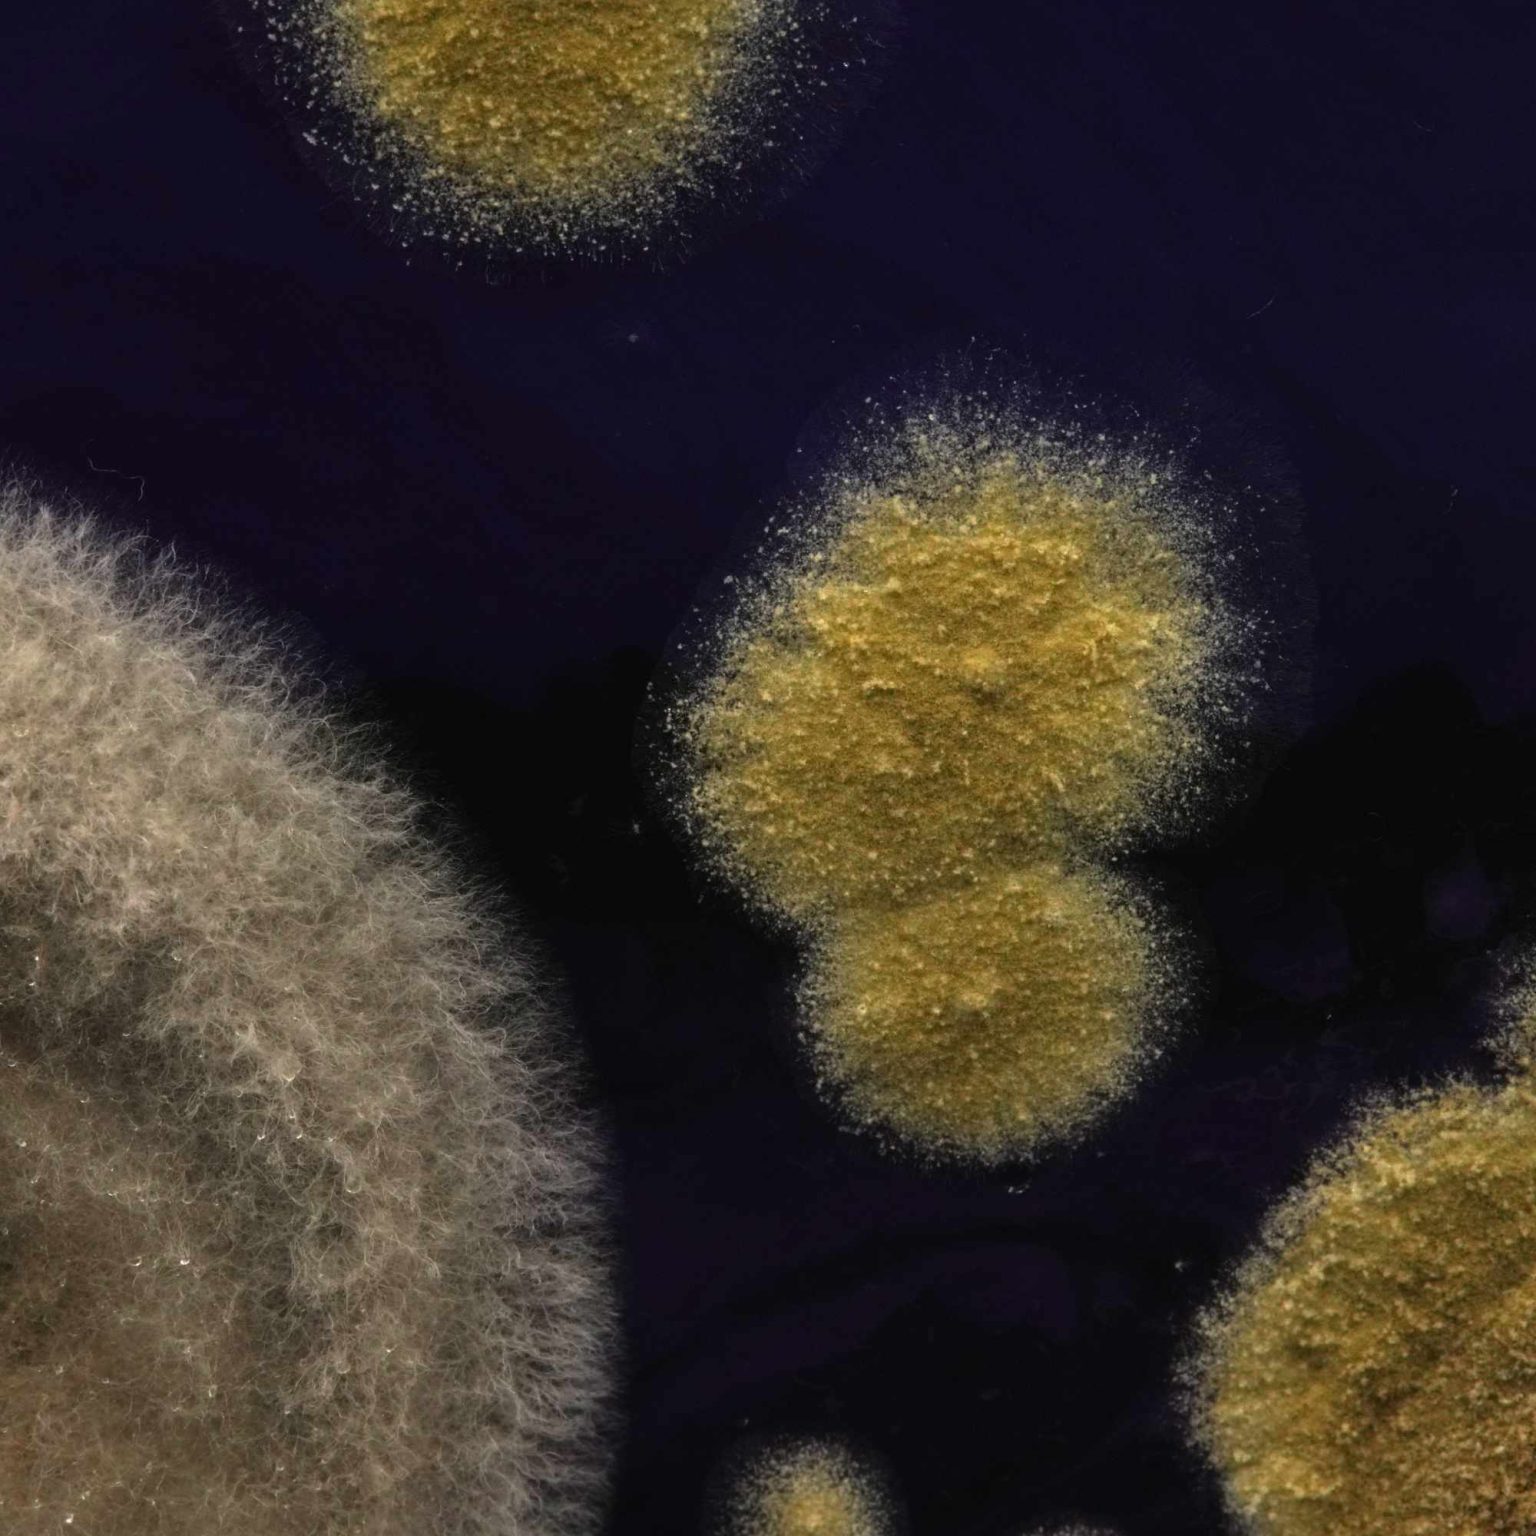
4
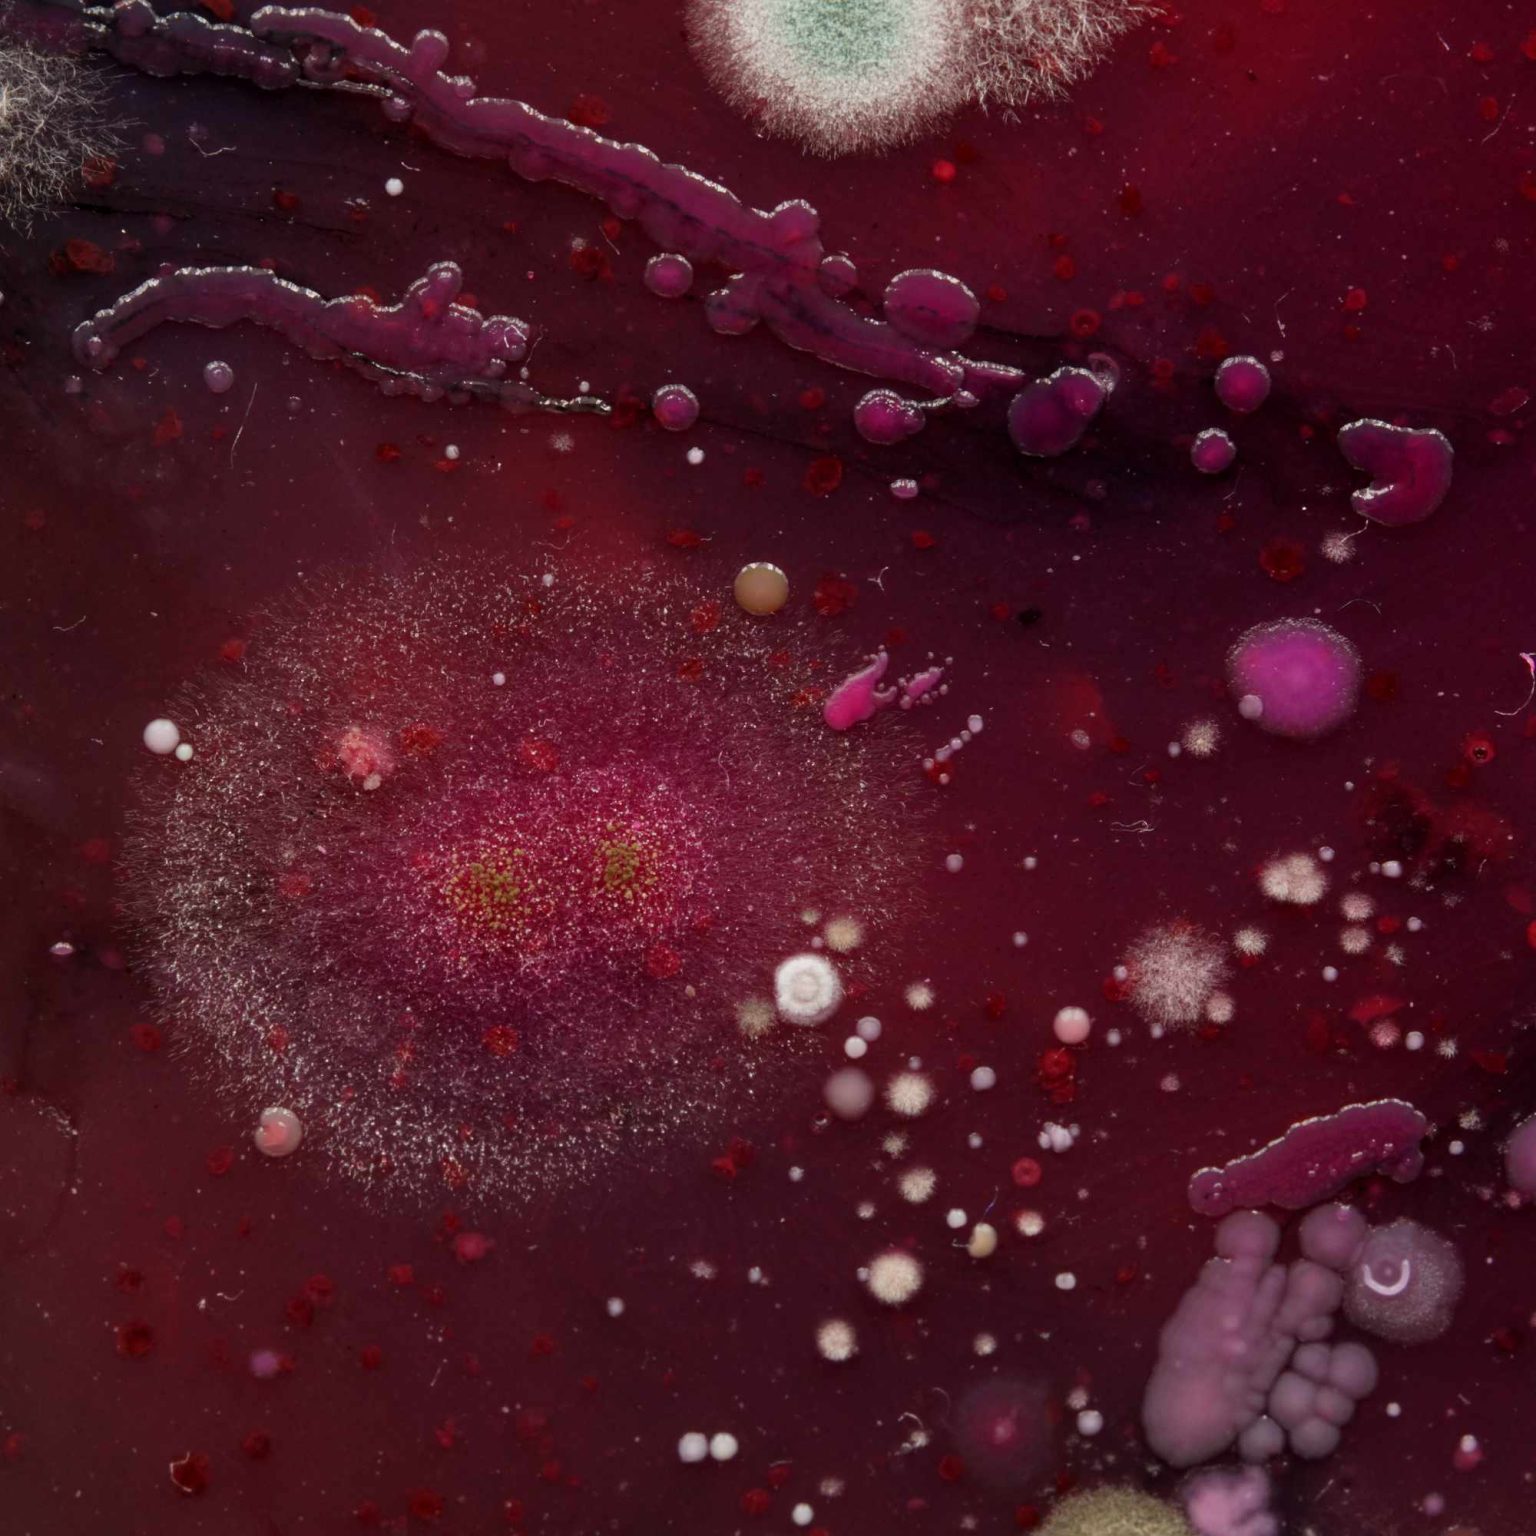
3
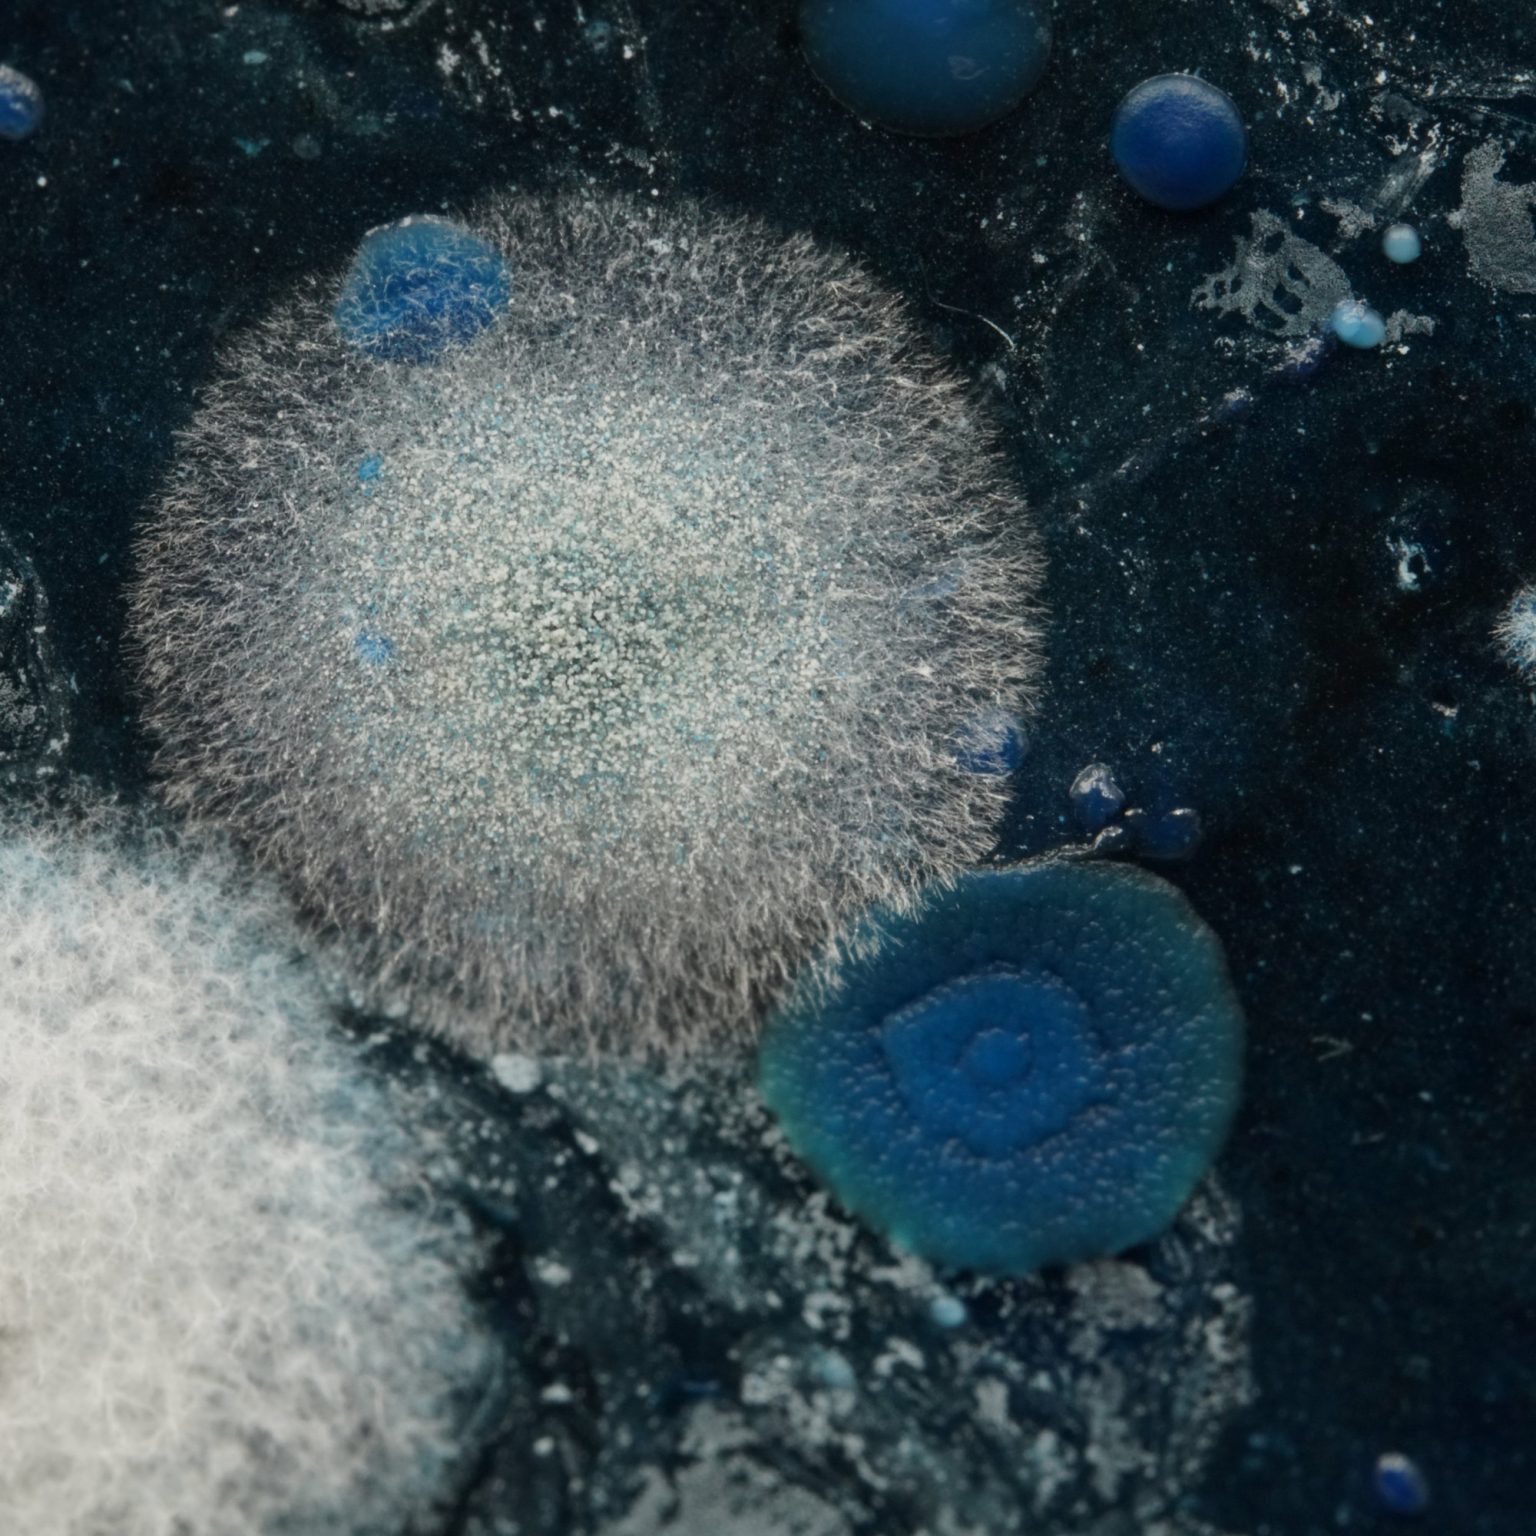
2
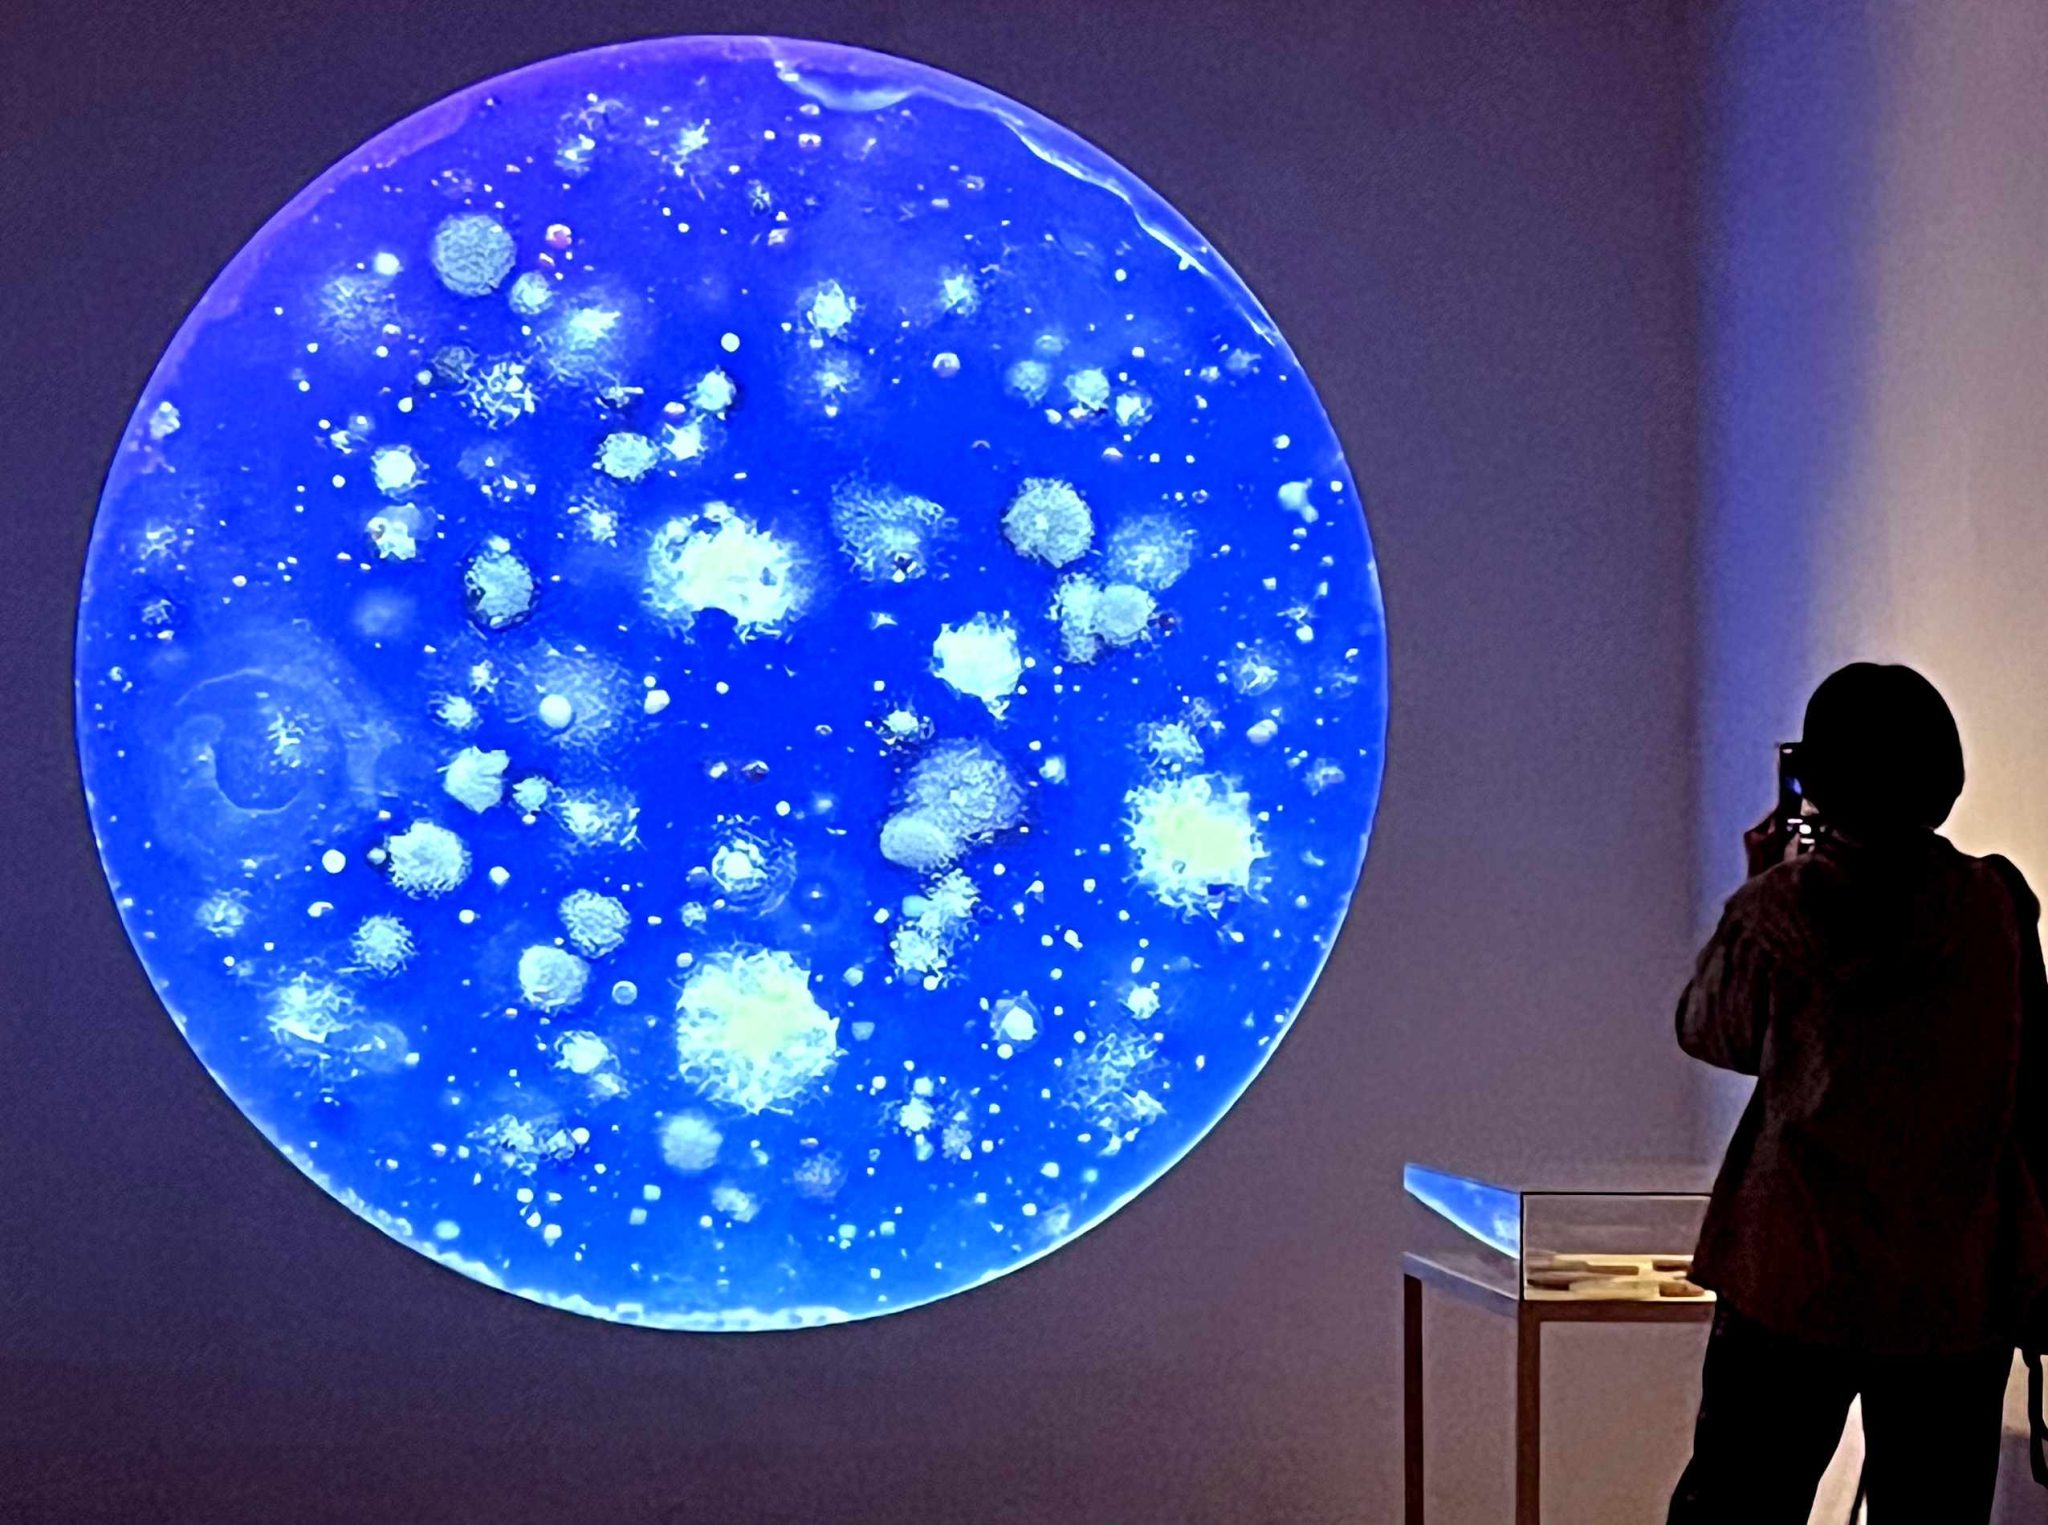
IMG_7057
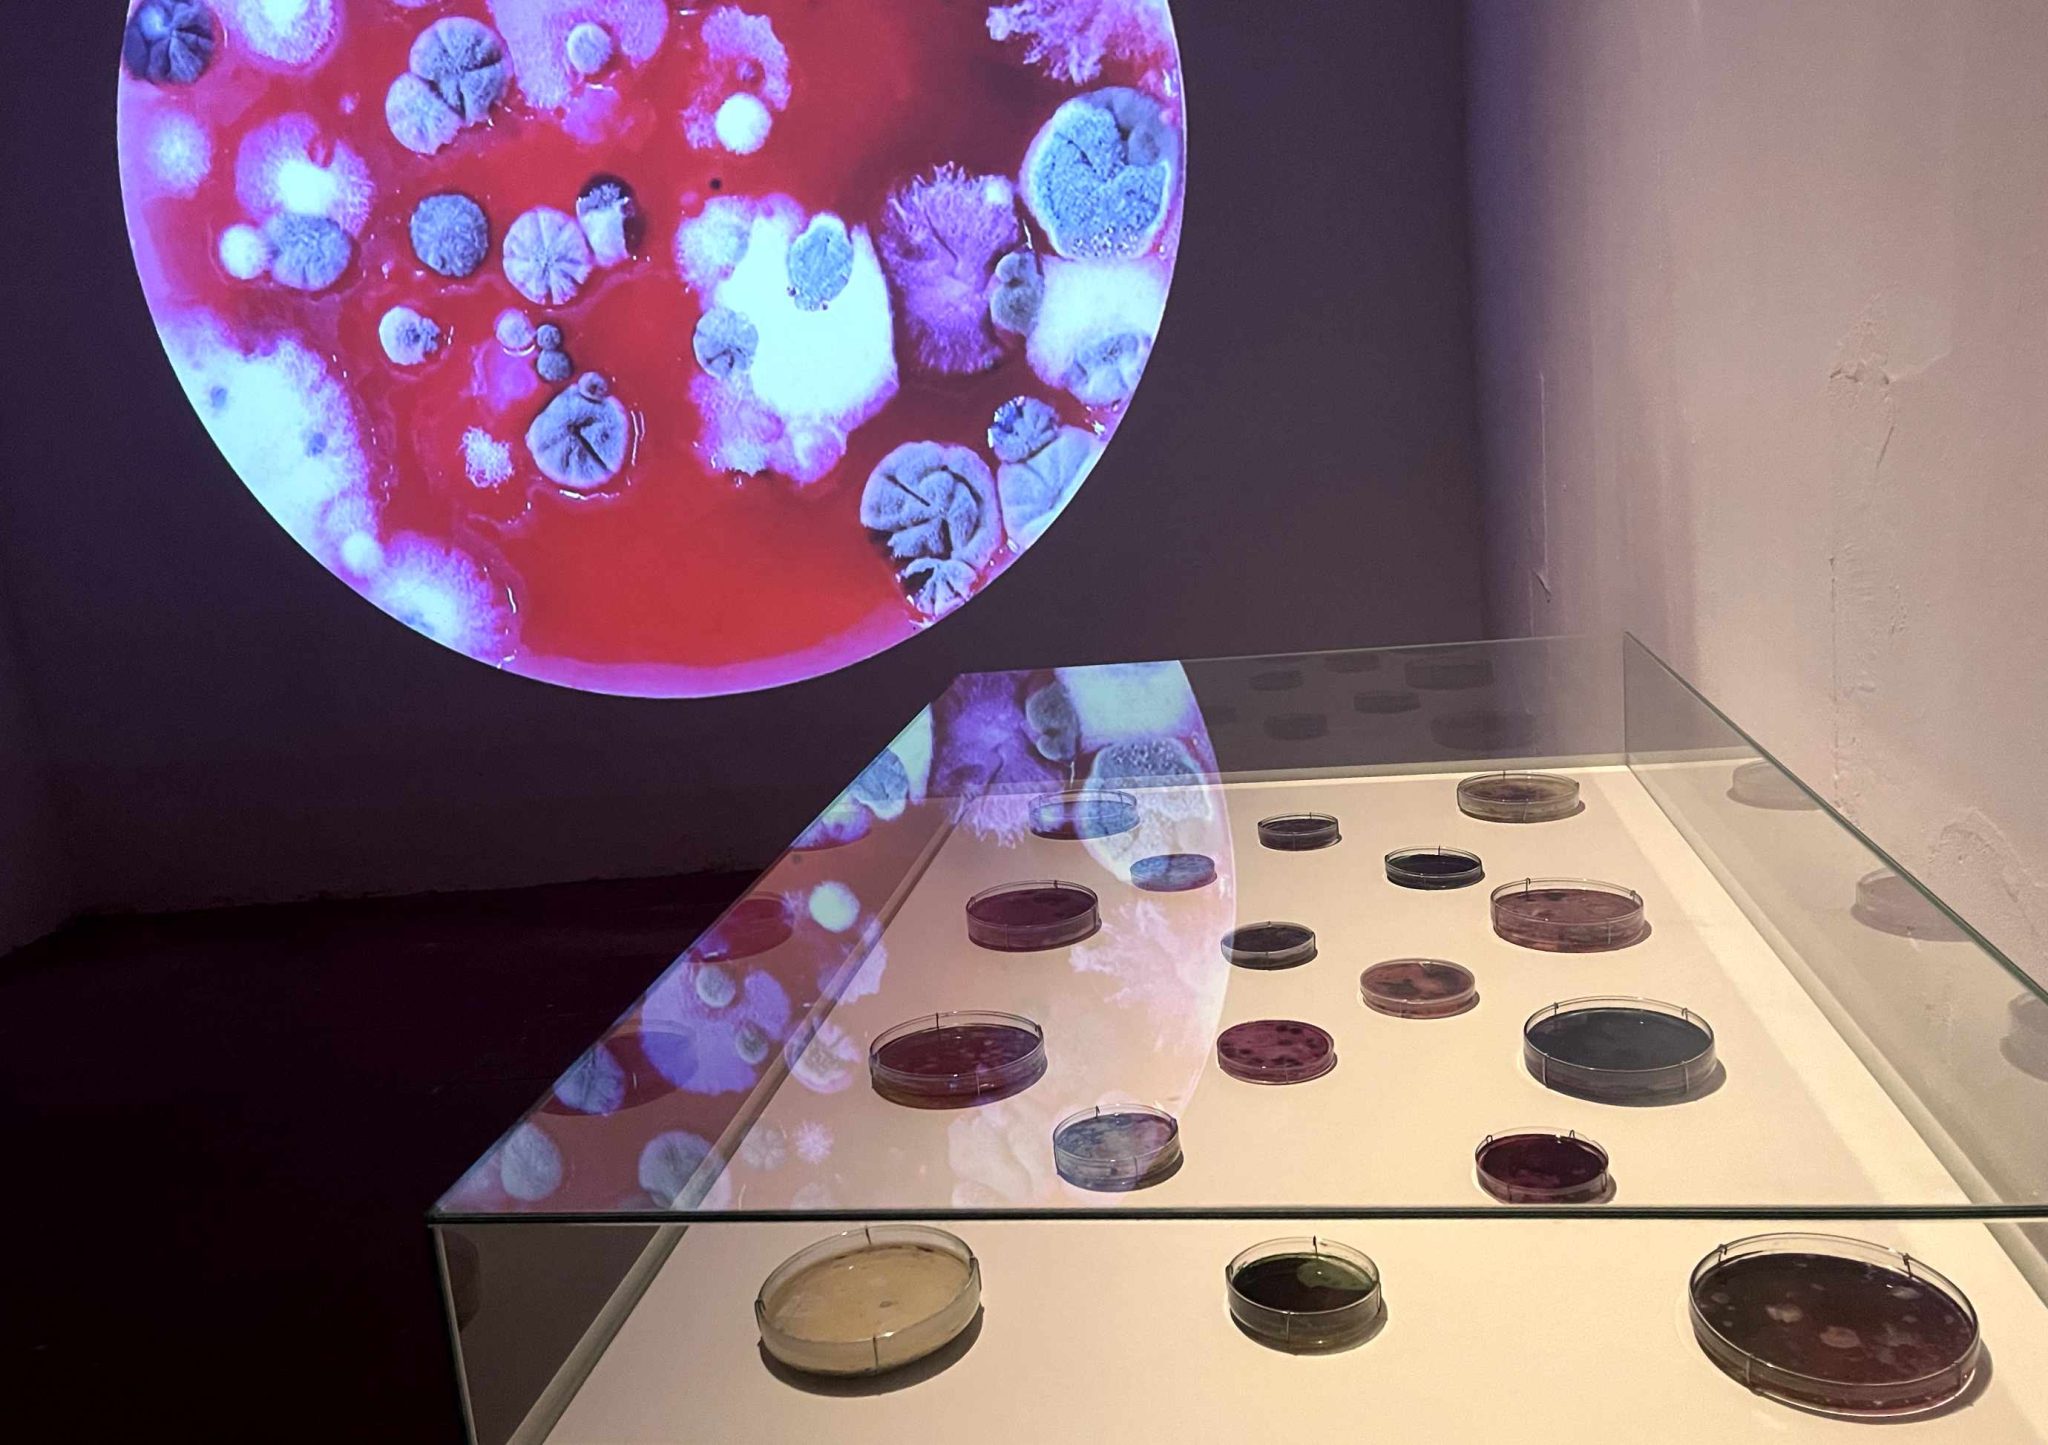
IMG_7115
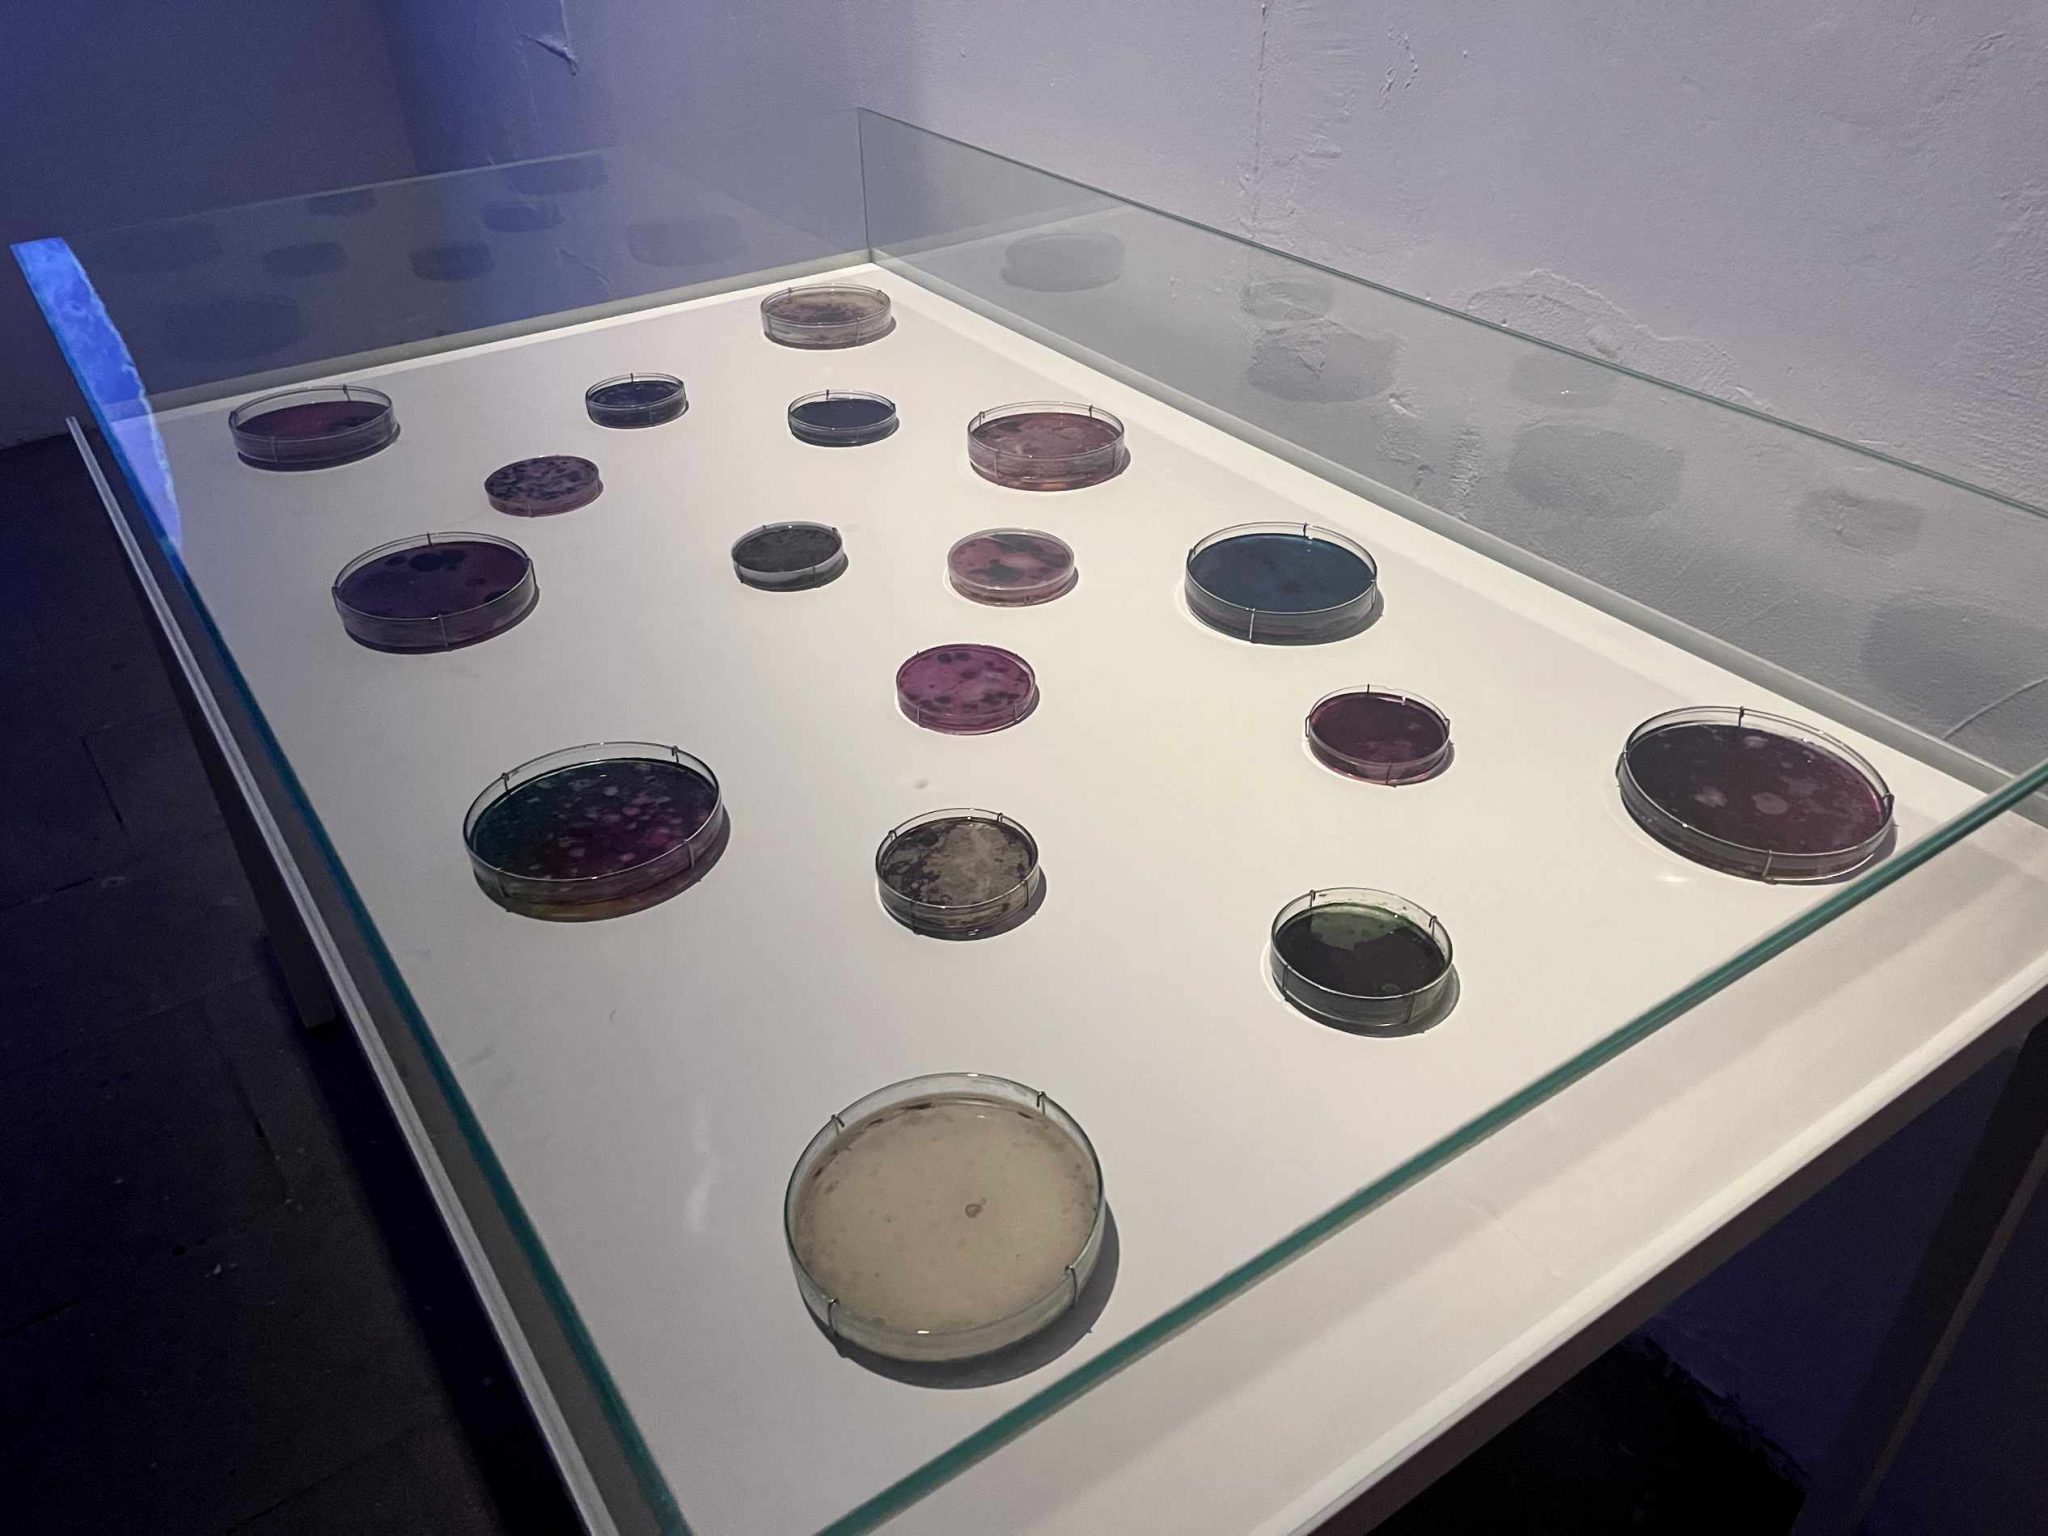
IMG_7114

MICROuniversos es un proyecto de investigación y creación artística que explora la vida microscópica a través del cultivo, estudio y observación de microorganismos presentes en el aire, recolectados en diferentes entornos atmosféricos del planeta: Bogotá (2020), Bergen (2020), Madrid (2021–2025), Ljubljana (2023), el Valle del Tiétar (2024). El proyecto combina una documentación fotográfica macroscópica detallada del crecimiento y desarrollo de los cultivos con técnicas de conservación que permiten mantener estructuras celulares, micelares y coloniales en placas de Petri.
A través del uso de la microbiología y la macroscopia como herramientas metodológicas, la investigación busca establecer vínculos entre lo micro y lo macro, explorando el carácter “cósmico” en las formas de existencia de estos organismos. Los microorganismos son presentados como galaxias, constelaciones o mundos extraterrestres, mediante proyecciones en formato domo (planetario), video instalaciones, performances en vivo y exhibiciones de la colección.
Iniciado en 2019 en el marco de BioCrea del Medialab Prado, MICROuniversos adquirió su impulso durante la pandemia de COVID-19, en la reflexión de la biodiversidad del aire. Durante el confinamiento se desarrolló el portableLAB, un laboratorio portátil de microbiología que ha permitido continuar la investigación en distintos contextos geográficos, promoviendo una observación expandida y móvil de los fenómenos de la vida.

«MICROuniversos se acerca a preguntas sobre el origen desde la vida orgánica interpretada como memoria del universo. Da lugar a interrogantes sobre los límites de lo que llamamos vivo, como formas de ser que se replican y evolucionan en el universo a todos sus niveles. Tanto el telescopio como el microscopio han sido herramientas usadas por la ciencia, y han permitido revisar la existencia de universos ocultos a simple vista. En ambos casos nos han permitido acercarnos a seres inimaginables a través de la generación de imágenes: como puede ser la de un agujero negro o una constelación o una congregación de galaxias o una colonia de microorganismos, bacterias, hongos y levaduras. Las interacciones biológicas momentáneas y únicas que se dan al interior de estas cajas petri, generan entramados de estructuras y formas que se asemejan a imágenes en el telescospio abriendo un ciclo de posibilidades de especulación sobre las fronteras y similitudes entre lo micro y lo macro. La astrobiología establece un campo experimental donde Microuniversos Bogotá buscó entrecruzar niveles perceptivos de las escalas del universo y su relación con el origen donde en los microorganismos y sus complejas colonias se presenta una evidencia de una entropia negativa que vemos presente en la transmutación de la materia y se desvela en formas con un orden, desde la espontaneidad y veracidad de la vida invisible que nos rodea.»
Festival suratómica 2020
Exhibiciones
nostalgía de futuro: Atravesando en colapso
2025-26. Centre d’art La Capella. Barcelona.
Esta exhibición colectiva reflexiona sobre los imaginarios sobre el futuro, presentando una serie de obras artísticas que representan alternativas al colapso. Dentro de la obras se presentó una video instalación que compila una serie de fotografías de microuniversos presentados en una proyección de gran formato, el laboratorio portátil y parte de la colección en placas de Petri.

ExpoDOC
2022. Universidad Complutense de Madrid. Instalación.
MICROuniversos hizo parte de la exhibición colectiva EXPODOC 2022 de la Facultad de Arte de la Universidad Complutense de Madrid. Para la muestra, se elaboró una montaje a partir de la selección de 12 medios de cultivo en cajas de Petri.












A|Cerca Del Origen
2020. Exhibición Online. Festival Suratómica. Colombia.
Como parte del Festival Suratómica celebrado on-line realicé un video performance con un teléfono móvil, varios lentes y medios de cultivo en placas de petri colectados del aire de Bogotá.
Video Performance
Película
Un viaje Espacio temporal por la vida microscópica del aire
Mediometraje en formato domo.
Película para formato DOMO-4K (25 minutos largo / 8 minutos corto).
Proyección en formato domo (simulación)
Residencia
Microuniversos Bergen 2020
2020. Residencia Quarentena. Festival Piksel. Bergen, Noruega.
En consecuencia de la cuarentena obligatoria de 10 días por ingreso a Noruega durante la pandema del Covid-19, el Festival Piksel convocó proyectos para hacer una residencia de creación. Para este fin, y teniendo en cuenta las condiciones del espacio, llevé a esta residencia una maleta (Portable-Lab) con los instrumentos necesario para el cultivo y observación de microorganismos de forma casera. Durante ese tiempo estuve experimentando con diferentes medios de cultivo de microorganismos en cajas petri usando los residuos orgánicos de cocina, haciendo diferentes combinaciones que variaban según los platos que preperaba para mí. Estos medios fueron expuestos a la atmósfera (aire, humedad) del vecinario alrededor de mi residencia, buscando hacer visible los microorganismos a mi alrededor y evidente su riqueza microscópica.
Cada caja petri desveló una paisaje microscópico único y cambiante (microuniverso), imágenes pintadas a partir de las complejas estructuras celulares e interacciones biológicas. Se tomaron fotografías del proceso de crecimiento, y las mejores fotos fueron usadas en un video de alta resolución donde se mezclaban las imágenes. Dicho video fue presentado durante el festival en fachadas de edificios en la ciudad de Bergen, en gran formato. También, usando técnicas de bellas artes, fueron conservadas las estructuras celulares, colonias y micelos visibles en las cajas petri como parte de la exhibición de resultados en el Piksel Studio.
Proyección en fachada de iglesia en Bergen
Muestra de microuniversos en Piksel Studio






PortableLab
2020. Online
El proyecto microuniversos comienza días antes del confinamiento estricto de la pandemia del covid-19 con el prototipo de un laboratorio portátil de microbiología: en una maleta de mano. Reuní y ordené los materiales e instrumentos necesarios para preparar medios de cultivo microbianos.